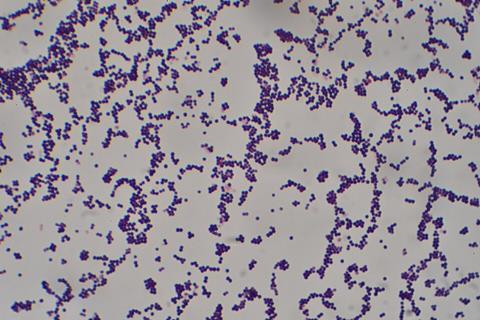
Staphylococcus_aureus_Gram_stain

Bacteria are a major cause of infections and death within hospital settings, in part due to the rising number of antibiotic resistance.
In the United States, antibiotic-resistant bacteria are involved in more than 2 million infections and cause 23,000 deaths annually. There’s a growing need for new options that can both treat infections and limit resistance.
In a recent study, University of Michigan researchers developed copper-loaded starch nanoparticles that can be broken down by specific bacteria to release antibacterial copper molecules.
They hope that these nanoparticles can be used to target microbial communities, called biofilms, which account for 50-70% of healthcare-associated infections.
Why nanoparticles fail
Nanoparticles have been previously investigated to target bacteria. However, they fail to work in clinical settings because they are not soluble in water and are not stable enough to work properly.
Additionally, they need to be non-toxic while remaining in the body at high enough concentrations to be effective.
In the present study, the researchers used starch, which can act as a stabilizer and carrier for copper nanoparticles.
Starch has a positive charge that is attracted to the negative charge on the surface of bacteria.
Healthcare-associated infections
The researchers found that the copper-loaded starch nanoparticles they developed were effective against Staphylococcus aureus, a common cause of healthcare-associated infections, and Bacillus subtilis.
Since the charge on the nanoparticles helps them target bacteria directly, they were more effective than what was seen in previous studies.
The team also found that the nanoparticles worked better when bacterial growth conditions favored starch degradation.
“Copper-loaded starch nanoparticles act like Trojan horses,” said J. Scott VanEpps, Associate Professor of Emergency Medicine and Biomedical Engineering and Associate Director of Weil Institute.
“Some bacteria break down the starch, releasing antibacterial copper molecules.”
Breaking down starch
Although S. aureus cannot break down starch, B. subtilis can by using the enzyme amylase.
These results suggest that copper-loaded starch nanoparticles can also be used to target microbial communities, often found in wound infections, especially if multiple bacterial species can make amylase.
The researchers are interested in building a database of nanomaterials that have been tested on bacteria.
They aim to use machine learning to guide the development of new nanoparticles.
Beyond guesswork
“Currently, developing nanoparticles has involved guesswork, which is expensive and inefficient,” VanEpps said. “By going through everything that worked, or didn’t, we can pursue intelligent nanoparticle design.”
Additional authors: Nathan A. Jones, Usha Kadiyala, Benjamin Serratos and Joerg Lahann
Funding/disclosures: VanEpps was supported by the National Institutes of Health, National Institute for Allergy and Infectious Diseases, grant number K08AI128006. Lahann received support from the National Science Foundation and grant number 2243104, Center for Complex Particle Systems.
Paper cited: “Targeting of Bacteria Using Amylase-Degradable, Copper-Loaded Starch Nanoparticlea,” Antibiotics. DOI: 10.3390/antibiotics15010056







No comments yet